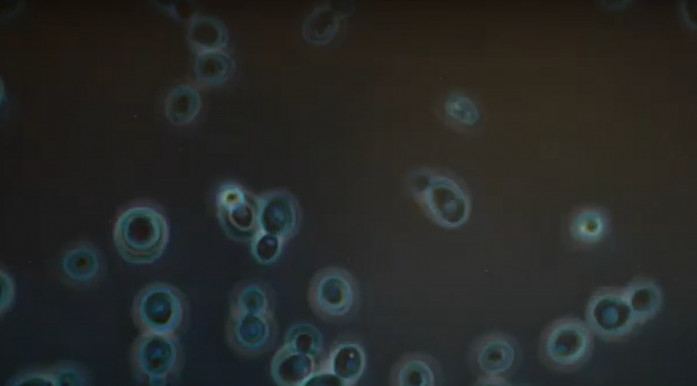

Vajon mi az öregedés? Milyen szakmákra lesz szükség 50-100 év múlva? Hogyan és kik fogják irányítani a társadalmakat? Mi lesz a vallásokkal? Mi lesz a ...?
A Klubrádió tudományos, ismeretterjesztő műsorában, az Utópiában a jövőkutatás legizgalmasabb kérdéseit boncolgatjuk hétről hétre, kiemelkedő tudósok és szakértők segítségével.
Az Utópia már podcast formában is hallgatható.
Iratkozzon fel a műsorra kedvenc online platformján!
Spotify
Apple podcast
Google podcast